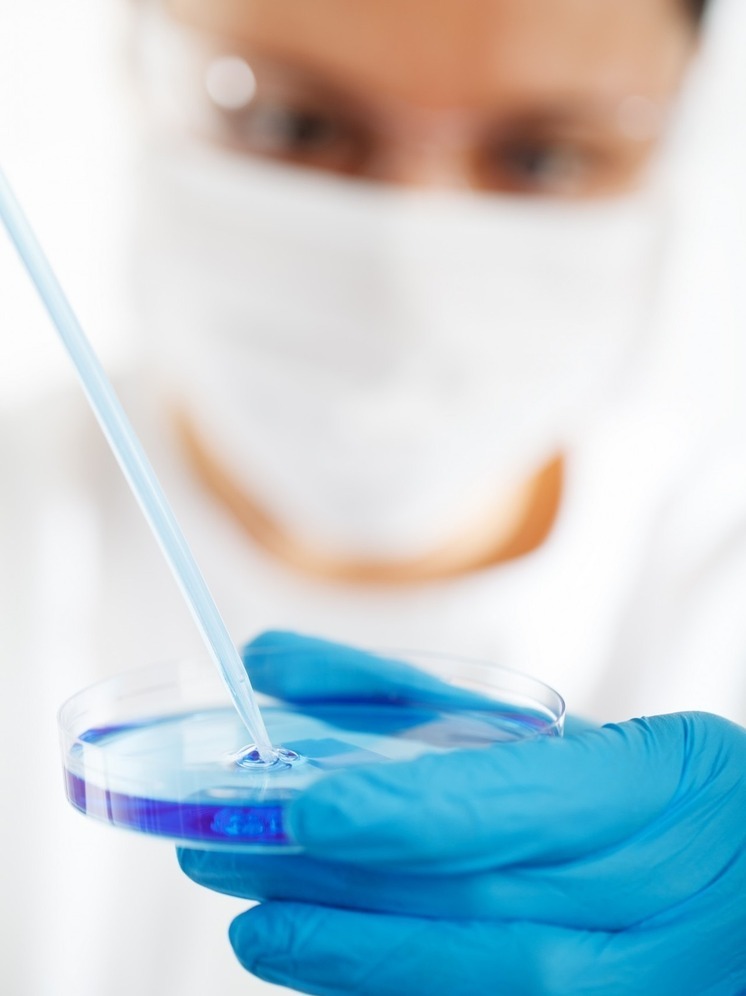
Научный центр построят в Ленинском районе Нижнего Новгорода

В Нижнем Новгороде, в районе метро «Пролетарская», построят научно-исследовательский центр, соответствующее разрешение выдано областным министерством строительства.
Объект будет располагаться на территории в границах улиц Переходникова, Новикова-Прибоя и проспекта Ленина. Научный центр, вероятно, будет заниматься лабораторными исследованиями пищевых продуктов.
Согласно проектной документации, планируется возведение двухэтажного здания. Помимо этого, в непосредственной близости будет построен трехэтажный спортивный комплекс, включающий в себя подземную автостоянку, рассчитанную на 70 парковочных мест.